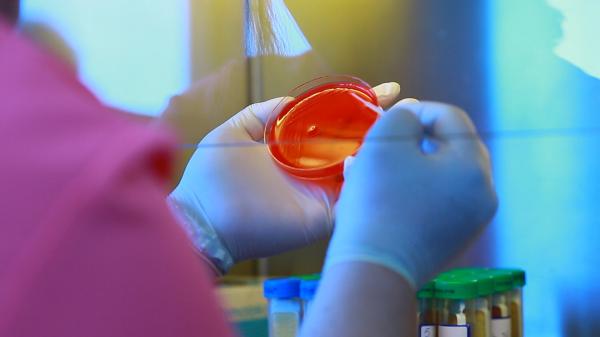
14 bătrâni, operaţi de cataractă, s-au infectat în spital. Reprezentanţii spitalului spun că nu sunt de vină, ancheta DSP îi contrazice: bacteria vine chiar din sala de operaţie

Sănătate
Știri și video din domeniul sănătate. Știri din medicină, asistență sanitară, nutriție, fitness
Știri și video din domeniul sănătate. Știri din medicină, asistență sanitară, nutriție, fitness

De la explozia preţurilor, trecem la o altă explozie... a cazurilor de varicela. În Timiş, în ultima...
pe 24.03.2022 la 12:44
Suntem pregătiți in cazul unui incident nuclear. Antibiotice Iaşi a produs cele 30 de milioane de comprimate de iodură de...
pe 23.03.2022 la 22:10
Se spune: “Fii o binecuvântare pentru cineva și ești binecuvântat”. Este o realitate crudă și...
pe 23.03.2022 la 18:15
Ministrul Sănătăţii, Alexandru Rafila, a declarat marţi că instaurarea unor noi restricţii în contextul pandemiei de...
pe 23.03.2022 la 13:55
Ministerul Sănătăţii a anunțat pentru miercuri, 23 martie 2022, că, în ultimele 24 de ore, au fost...
pe 23.03.2022 la 13:22
După cinci valuri de Covid acum pare că vine valul virozelor . Revenirea la normalitate a umplut camerele de gardă din spitale....
pe 22.03.2022 la 20:52
Avem cele 30 de milioane de comprimate de iodură de potasiu promise de Ministerul Sănătăţii. S-a lucrat zi și noapte în...
pe 22.03.2022 la 20:19
Antibiotice Iași, companie de importanță strategică pentru România, a anunțat că, în data de 21 martie 2022, a...
pe 22.03.2022 la 16:55
Ministerul Sănătăţii a anunțat pentru marţi, 22 martie 2022, că, în ultimele 24 de ore, au fost...
pe 22.03.2022 la 13:22
Numărul de cazuri Covid a revenit pe creștere chiar înainte de sărbătorile de Paște, în loc să ajungă la un...
pe 21.03.2022 la 18:11
Ministerul Sănătăţii a anunțat pentru luni, 21 martie 2022, că, în ultimele 24 de ore, au fost...
pe 21.03.2022 la 13:22
Dacă fizic ştim cât de mult ne ajută sportul, puţini sunt cei care au idee cât de multe beneficii aduce şi...
pe 20.03.2022 la 20:30
Pandemia nu se dă dusă aşa uşor. După renunţarea la restricţii, numărul de cazuri de COVID 19 este în creştere...
pe 20.03.2022 la 19:44
Ministerul Sănătăţii anunţă că, în ultimele 24 de ore, au fost raportate 2.241 cazuri noi de persoane infectate cu...
pe 20.03.2022 la 13:10
În ultimele 24 de ore au fost raportate 3.168 de cazuri noi de COVID-19, cu 120 mai multe decât în ziua...
pe 19.03.2022 la 13:16
Mai multe echipe de medici de la Târgu Mureş, Bucureşti şi Cluj au prelevat ficatul, rinichii, cornee şi os de la un...
pe 19.03.2022 la 12:25
Spune-mi cum dormi, ca să-ți spun cât de sănătos ești. Un studiu recent a arătat că persoanele care dorm cu...
pe 18.03.2022 la 18:41
Un avertisment venit din partea specialiştilor în sănătate. Viitoarele sezoane de alergii la polen vor începe mult...
pe 17.03.2022 la 13:33
Poliomielită şi difterie. Sunt două dintre bolile eradicate în ţara noastră, dar care ar putea reveni o dată cu valul...
pe 16.03.2022 la 21:00
Sovata, una dintre cele mai cunoscute staţiuni din România, nu duce lipsă de turişti. Aproximativ 100.000 de oameni...
pe 16.03.2022 la 17:37
Ministerul Sănătăţii a anunțat pentru miercuri, 16 martie 2022, că, în ultimele 24 de ore, au fost...
pe 16.03.2022 la 13:14
La loc comanda. După doi ani de zile în pandemie, spitalele din România au nevoie de reorganizare. Dacă în cele...
pe 15.03.2022 la 20:07
Există o preocupare și se investighează medical cazurile de persoane venite din Ucraina ce pot ridica suspiciune de...
pe 15.03.2022 la 15:15
Abia am răsuflat uşuraţi că am scăpat de valul COVID, dar a venit valul virozelor. Asta pentru că nu mai suntem obligaţi să...
pe 14.03.2022 la 19:40
Sezonul răcelilor și al gripei e pe cale să se sfârșească, dar nu e cazul să renunți la pachetul de șervețele, mai...
pe 14.03.2022 la 15:24
Primăvara a venit, anul acesta, cu temperaturi scăzute şi cu un val de viroze respiratorii. În prima săptămână...
pe 14.03.2022 la 14:03
Grupul de Comunicare Strategică a anunțat pentru luni, 14 martie 2022, că, în ultimele 24 de ore, au fost...
pe 14.03.2022 la 13:08
Comitetul Național de Coordonare a Activităților privind Vaccinarea împotriva COVID-19 (CNCAV) a prezentat duminică,...
pe 13.03.2022 la 17:13
Incidenţa cumulată a cazurilor de coronavirus a ajuns duminică, 13 martie 2022, la 10.09 cazuri la mia de locuitori,...
pe 13.03.2022 la 13:02
Lista cazurilor de coronavirus pe judeţe a fost actualizată duminică, 13 martie 2022. Conform reprezentanților Grupului de...
pe 13.03.2022 la 13:01
Grupul de Comunicare Strategică a anunțat pentru duminică, 13 martie 2022, că, în ultimele 24 de ore, au fost...
pe 13.03.2022 la 12:55
Comitetul Național de Coordonare a Activităților privind Vaccinarea împotriva COVID-19 (CNCAV) a prezentat...
pe 12.03.2022 la 17:15
Incidenţa cumulată a cazurilor de coronavirus a ajuns sâmbătă, 12 martie 2022, la 10.9 cazuri la mia de locuitori,...
pe 12.03.2022 la 13:25
Lista cazurilor de coronavirus pe judeţe a fost actualizată sâmbătă, 12 martie 2022. Conform reprezentanților Grupului...
pe 12.03.2022 la 13:19
Grupul de Comunicare Strategică a anunțat pentru sâmbătă, 12 martie 2022, că, în ultimele 24 de ore, au fost...
pe 12.03.2022 la 13:01
Comitetul Național de Coordonare a Activităților privind Vaccinarea împotriva COVID-19 (CNCAV) a prezentat vineri,...
pe 11.03.2022 la 16:16
Grupul de Comunicare Strategică a anunțat pentru vineri, 11 martie 2022, că, în ultimele 24 de ore, au fost...
pe 11.03.2022 la 13:08
Incidenţa cumulată a cazurilor de coronavirus a ajuns vineri, 11 martie 2022, la 11.78 cazuri la mia de locuitori, potrivit...
pe 11.03.2022 la 13:03
Lista cazurilor de coronavirus pe judeţe a fost actualizată vineri, 10 martie 2022. Conform reprezentanților Grupului de...
pe 11.03.2022 la 12:59
Comitetul Național de Coordonare a Activităților privind Vaccinarea împotriva COVID-19 (CNCAV) a prezentat joi,...
pe 10.03.2022 la 17:36
Lista cazurilor de coronavirus pe judeţe a fost actualizată joi, 10 martie 2022. Conform reprezentanților Grupului de Comunicare...
pe 10.03.2022 la 14:12
Grupul de Comunicare Strategică a anunțat pentru joi, 10 martie 2022, că, în ultimele 24 de ore, au fost...
pe 10.03.2022 la 13:05
Incidenţa cumulată a cazurilor de coronavirus a ajuns joi, 10 martie 2022, la 12.77 cazuri la mia de locuitori,...
pe 10.03.2022 la 12:30
Comitetul Național de Coordonare a Activităților privind Vaccinarea împotriva COVID-19 (CNCAV) a prezentat miercuri,...
pe 09.03.2022 la 17:15
Lista cazurilor de coronavirus pe judeţe a fost actualizată miercuri, 9 martie 2022. Conform reprezentanților Grupului de...
pe 09.03.2022 la 13:39
Incidenţa cumulată a cazurilor de coronavirus a ajuns miercuri, 9 martie 2022, la 13.41 cazuri la mia de locuitori, potrivit...
pe 09.03.2022 la 12:04
Toate restricțiile legate de Covid-19 au fost ridicate brusc, însă fără un plan pentru protejarea celor vulnerabili,...
pe 09.03.2022 la 10:40
Grupul de Comunicare Strategică a anunțat pentru miercuri, 9 martie 2022, că, în ultimele 24 de ore, au fost...
pe 09.03.2022 la 10:25
Pandemia de COVID-19 nu s-a încheiat, iar distribuţia de vaccinuri împotriva noului coronavirus la nivel mondial...
pe 09.03.2022 la 10:21
Comitetul Naţional pentru Situaţii de Urgenţă a aprobat, marţi, o hotărâre privind abrogarea unei decizii luate de CNSU...
pe 08.03.2022 la 20:55